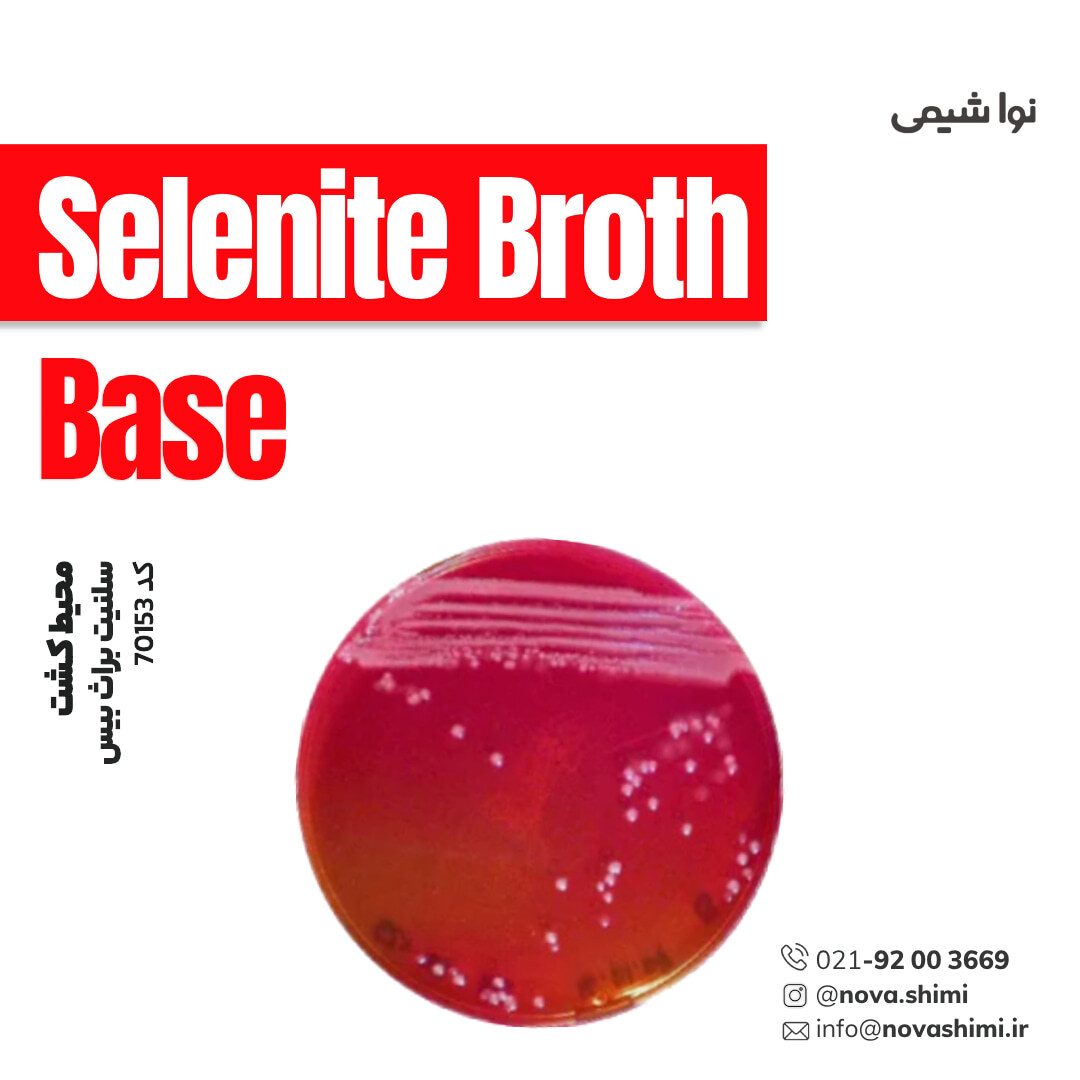
محیط کشت سلنیت براث (Selenite Broth (Base))

محیط کشت سلنیت براث (Selenite Broth (Base))
مشخصات فنی محیط کشت Selenite Broth:
1. برند: Merck Millipore
2. کاربرد: افزایش جمعیت سالمونلا در نمونههای غذایی، آب و مدفوع پیش از کشت افتراقی.
3. فرم فیزیکی: پودری (powder)
4. حجم بسته: 500 گرم
محیط کشت Selenite Broth چیست؟
سلنیت براث (Base) محیط غنیکنندهای است که با مهار باکتریهای مزاحم، امکان افزایش انتخابی سالمونلا را قبل از جداسازی فراهم میکند. شرکت نُـواشیمی، به عنوان یکی از تامین کنندگان مواد آزمایشگاهی و محیط کشت برند مرک و سیگما آلدریچ، آماده ارائه خدمات فروش محیط کشت Selenite Broth مرک کد 70153 به شما عزیزان خواهد بود. برای دریافت اطلاعات فنی و استعلام قیمت محیط کشت سلنیت براث مرک، از طریق شماره 02192003669 با کارشناسان فروش نُـوا شیمی تماس حاصل فرمایید.
برای آشنایی بیشتر با ویژگیها و مشخصات محصول، میتوانید با کلیک روی هر عنوان، به توضیحات تکمیلی در زیرعنوانهای مربوطه دسترسی پیدا کنید.
مشخصات محصول (Product Specifications)
مشخصات فنی محیط کشت Selenite Broth مرک (Product Specifications)
در جدول زیر میتوانید مشخصات فنی محیط کشت سلنیت براث بیس مرک را مشاهده کنید.
ویژگی | توضیحات |
|---|---|
نام محصول | Selenite Broth (Base) |
برند / تولیدکننده | Millipore – NutriSelect® Plus |
کد محصول | 70153 |
فرم فیزیکی | پودر خشک |
کیفیت (Quality Level) | 100 |
Shelf Life | مدت نگهداری محدود (تاریخ انقضا روی لیبل) |
pH نهایی | 7.0 ± 0.2 در 25°C |
ترکیبات اصلی | Bacteriological Peptone (5 g/L) – Lactose (4 g/L) – Sodium Phosphate (10 g/L) |
نیاز به مکمل | 4 g/L سدیم هیدروژن سلنیت (Cat No. 71658) |
مناسب برای | غنیسازی انتخابی سالمونلا و شیگلا |
کاربردها | نمونههای بالینی، محیطی، غذایی، میکروبیولوژی |
سطح انتخابپذیری | انتخابی برای Salmonella spp. و Shigella spp. |
UNSPSC Code | 41106200 |
NACRES | NA.74 |
کلاس نگهداری | 11 – مواد جامد قابل احتراق |
WGK | 3 |
خطرپذیری | Eye Irrit. 2 – Skin Irrit. 2 – STOT SE 3 |
تجهیزات حفاظت فردی | دستکش، عینک ایمنی، ماسک گردوغبار N95 |
برای مشاهده اطلاعات کامل محصول در سایت مرک و جزئیات کاربردی آن، بر روی Selenite Broth (Base) کلیک کنید. شرکت نُـوا شیمی، تأمینکننده انواع محیط کشت برندهای معتبر مانند مرک و سیگما آلدریچ است و امکان خرید آسان و مطمئن این محصولات آزمایشگاهی را برای شما فراهم میکند.
آنالیز و کیفیت (Analysis Note)
ویژگیهای آنالیزی و کیفیت (Analysis Note)
Appearance (ظاهر فیزیکی): پودر خشک و یکنواخت، رنگ کرم مایل به بژ، کاملا همگن
pH-value (در 25°C، محلول آمادهشده): 7.0 ± 0.2
Form (فرم فیزیکی): پودر محلول در آب، مناسب برای تهیه سریع محیط غنیسازی
Growth Promotion Test (تست رشد میکروبی): غنیسازی مؤثر Salmonella spp. و Shigella spp.؛ مهار فلور همراه روده مانند E. coli
Selective Component (عامل انتخابی): نیازمند افزودن 4 g/L سدیم هیدروژن سلنیت (Sodium Hydrogen Selenite)
Selectivity (انتخابپذیری): مهار رشد باکتریهای رقابتی و تقویت رشد سالمونلاهای ضعیف یا آسیبدیده
Carbon/Nitrogen Sources (منابع غذایی): پیتون و لاکتوز برای تغذیه و کنترل رقابت با باکتریهای غیرهدف
Recovery Rate (نرخ رشد مجدد): بالا برای Salmonella spp. بهویژه در نمونههای بالینی و غذایی
Storage Condition (شرایط نگهداری): محیط خشک و تاریک، دمای 15–25°C
جدول راهنمای ویژگیهای آنالیزی محیط کشت Selenite Broth
ویژگی | توضیحات | تحلیل و اهمیت |
|---|---|---|
Appearance (ظاهر فیزیکی) | پودر خشک، یکنواخت و همگن، رنگ کرم مایل به بژ | یکنواختی نشاندهنده کیفیت تولید و توزیع مناسب مواد فعال محیط است. |
pH (25°C، محلول نهایی) | 7.0 ± 0.2 | pH خنثی عملکرد انتخابی سلنیت را بهینه کرده و رشد سالمونلا را افزایش میدهد. |
Form (فرم فیزیکی) | پودر قابل حل در آب | تهیه آسان، کاهش خطای آزمایشگاهی و جلوگیری از کلوخه شدن. |
Selective Component (عامل انتخابی) | نیازمند افزودن Sodium Hydrogen Selenite | ماده کلیدی برای مهار فلور همراه و تقویت غنیسازی سالمونلا و شیگلا. |
Selectivity (انتخابپذیری) | انتخابی برای سالمونلا و شیگلا | حذف مؤثر رقبا و افزایش حساسیت آزمونهای تشخیصی. |
Carbon/Nitrogen Sources (منابع غذایی) | پپتون و لاکتوز | کمک به رشد سالمونلا و محدودسازی رشد باکتریهای لاکتوزفورمنتر. |
Growth Promotion Test | عملکرد مؤثر در بازیابی Salmonella spp. | شاخص مهم تضمین کیفیت برای آزمایشهای روتین و بالینی. |
Recovery Rate (نرخ رشد مجدد) | کارآمد برای سالمونلاهای آسیبدیده | اهمیت بالا برای نمونههای بالینی و غذایی که سالمونلا در آنها استرسدیده است. |
Storage Condition (شرایط نگهداری) | 15–25°C، خشک و دور از نور | حفظ پایداری سلنیت و جلوگیری از افت کیفیت محیط. |
خرید محیط کشت سلنیت براث بیس NutriSelect® Plus Selenite Broth (Base)
خرید محیط کشت سلنیت براث بیس (NutriSelect® PlusSelenite Broth (Base)) کد 70153
محیط کشت سلنیت براث (Selenite Broth Base) یک محیط غنیسازی انتخابی و بسیار حساس است که برای جداسازی و افزایش جمعیت سالمونلا و شیگلا از نمونههای پیچیده مانند مدفوع، ادرار، آب، و مواد غذایی بهکار میرود. ترکیبات اصلی این محیط — شامل پپتونهای باکتریولوژیک، لاکتوز، و بافر فسفاتی — شرایط غذایی مناسب برای رشد باکتریهای هدف را فراهم میکنند، در حالیکه یونهای سلنیت (پس از افزودن مکمل سدیم هیدروژن سلنیت) با مهار رشد فلور طبیعی روده و سایر باکتریهای رقابتی، باعث افزایش انتخابپذیری محیط میشوند. این ویژگی باعث میشود سلنیت براث یک مرحله ضروری در فرایند شناسایی سالمونلا در آزمایشهای میکروبیولوژی بالینی، صنایع غذایی، و پایش محیطی باشد و امکان بازیابی میکروارگانیسمهای حساس و کمتعداد را فراهم کند.
کمپانی مِرک (MERCK)
شرکت مرک (Merck KGaA) یکی از قدیمیترین و معتبرترین کمپانیهای علمی و فناوری در جهان است که در سال 1668 در آلمان تأسیس شد و امروزه بهعنوان پیشگام جهانی در حوزههای مواد شیمیایی آزمایشگاهی، بیوتکنولوژی و داروسازی شناخته میشود. بخش مواد آزمایشگاهی مرک، طیف گستردهای از مواد شیمیایی با گریدهای مختلف از جمله آنالیتیکال، ACS، HPLC، و Suprapur® را ارائه میدهد که برای تحقیقات علمی، کنترل کیفیت صنعتی، و مصارف آموزشی کاربرد دارند.
شرکت نُـوا شیمی، تامین کننده مواد آزمایشگاهی محیط کشت
شرکت نُـوا شیمی، با سابقهای درخشان در تامین مواد آزمایشگاهی، استاندارد ها و تجهیزات آزمایشگاه، با دسترسی گسترده به محصولات برندهای معتبر داخلی و بینالمللی، تامین نیازهای صنایع، آزمایشگاههای تحقیقاتی و داروسازی را با رویکردی مدرن و دقیق دنبال میکند. در صورت نیاز به استعلام قیمت محیط کشت سلنیت براث بیس مرک کد 70153 یا سایر مواد آزمایشگاهی، استاندارد و رفرنسهای آزمایشگاهی کارشناسان ما از طریق خط ویژه 02192003669 آماده پاسخگویی و ارائه مشاوره تخصصی به شما خواهند بود.
کاربردهای محیط کشت Selenite Broth (Base)
مهمترین کاربردهای محیط کشت سلنیت براث بیس:
در ادامه، کاربردهای محیط کشت سلنیت براث مرک را مطالعه خواهیم نمود:
1. غنیسازی انتخابی سالمونلا از نمونههای بالینی: برای افزایش جمعیت Salmonella spp. از نمونههایی مانند مدفوع، ادرار و ترشحات بدن، خصوصاً زمانی که تعداد باکتری هدف کم و تحت تأثیر فلور طبیعی روده باشد.
2. جداسازی سالمونلا از نمونههای مواد غذایی: در آزمایشگاههای کنترل کیفیت مواد غذایی برای شناسایی آلودگی سالمونلا در محصولات خام، گوشت، مرغ، لبنیات و محصولات فرآوریشده استفاده میشود.
3. شناسایی سالمونلا در نمونههای محیطی: برای پایش کیفیت آب، فاضلاب، سطوح، و محیطهای صنعتی جهت ارزیابی وجود سالمونلا در فرآیندهای تولید و بستهبندی.
4. مناسب برای شناسایی سالمونلا تیفی (S. typhosa): این محیط بهطور خاص برای افزایش احتمال بازیابی S. typhi از نمونههای دشوار طراحی شده است.
5. افزایش حساسیت آزمایشهای تشخیصی قبل از انتقال به محیط جامد: پس از غنیسازی، نمونهها معمولا به محیطهایی مانند XLD، HEA یا Bismuth Sulfite Agar انتقال مییابند تا کلنیهای سالمونلا بهصورت افتراقی رشد کنند.
6. مهار رشد باکتریهای رقابتی: سلنیت موجود (پس از افزودن مکمل) رشد باکتریهای غیر هدف مانند E. coli و برخی Enterobacteriaceae را مهار میکند و درنتیجه دقت تشخیص را افزایش میدهد.
7. کاربرد در آزمایشگاههای میکروبیولوژی صنایع غذایی، پزشکی و دامپزشکی: به دلیل انتخابپذیری بالا و سازگاری با استانداردهای بینالمللی، در طیف گستردهای از آزمایشگاههای تحقیقاتی و کنترل کیفی استفاده میشود.
برای دریافت استعلام قیمت محیط کشت سلنیت براث مرک کد 70153، لطفا با شماره 02192003669 تماس حاصل فرمایید. کارشناسان ما آماده پاسخگویی به سوالات شما هستند.
نکات ایمنی
نکات ایمنی و نگهداری (Safety & Storage)
در ادامه نکات ایمنی استفاده از محیط کشت سلنیت براث مرک (NutriSelect® Plus Selenite Broth (Base)) برند مرک را مطالعه خواهیم نمود:
ویژگی | توضیح |
|---|---|
علائم هشدار | Warning |
گروه خطر | Eye Irrit. 2, Skin Irrit. 2, STOT SE 3 |
اثرات بالقوه | تحریک چشمها و پوست، تحریک سیستم تنفسی |
اقدامات احتیاطی | - از تنفس گرد و غبار خودداری شود (ماسک N95) - از تماس با پوست و چشمها جلوگیری شود (دستکش، عینک ایمنی) - هنگام کار در فضای دارای تهویه مناسب یا هود با جریان هوا کار شود |
اقدامات اضطراری در تماس با پوست | شستشو با آب و صابون به مدت حداقل ۱۵ دقیقه |
اقدامات اضطراری در تماس با چشم | شستشو با آب به مدت حداقل ۱۵ دقیقه، در صورت نیاز به پزشک مراجعه شود |
اقدامات اضطراری در استنشاق | خروج از محیط آلوده و تنفس هوای تازه، در صورت بروز علائم پزشکی مراجعه شود |
شرایط نگهداری | در بستهبندی اصلی، محیط خشک، دمای ۱۵–۲۵°C، دور از منابع حرارت و رطوبت |
کلاس نگهداری | 11 – Combustible Solids |
WGK | 3 |
اگر به دنبال محیط کشت سلنیت براث بیس (Selenite Broth (Base)) هستید، نُـوا شیمی همراهی مطمئن در مسیر تامین نیاز های شما خواهد بود. برای سفارش، دریافت مشاوره فنی و آگاهی از شرایط همکاری؛ از طریق شماره 02192003669 با تیم فروش در ارتباط باشید.
سوالات متداول (FAQ)
سوالات متداول درباره محیط کشت سلنیت براث بیس:
1. سلنیت براث چیست و چه کاربردی دارد؟
محیط کشت انتخابی برای تکثیر سالمونلا و شِیگلا از نمونههای بالینی، مواد غذایی و محیطهای محیطی است.
2. چه باکتریهایی را انتخاب میکند؟
این محیط کشت برای Salmonella spp. و Shigella spp. انتخابی است و رشد سایر میکروارگانیسمها را مهار میکند.
3. دمای مناسب انکوباسیون این محیط چقدر است؟
۳۵–۳۷ درجه سانتیگراد برای انکوباسیون استاندارد مناسب است.
4. چه مدت میتوان این محیط کشت را نگهداری کرد؟
بستهبندی محصول دارای تاریخ انقضا مشخص است و باید در محیط خشک و دمای ۱۵–۲۵°C نگهداری شود.
5. چگونه آمادهسازی میشود؟
ابتدا پودر را در آب مقطر حل کرده، به ازای مصرف، سدیم هیدروژن سلنیت به آن اضافه میشود و سپس به روش اتوکلاو استریل میگردد.
6. آیا برای استفاده بالینی و آزمایشگاهی ایمن است؟
هنگام کار با پودر از ماسک N95، دستکش و عینک ایمنی استفاده شود و از استنشاق گرد و غبار خودداری شود.
7. آیا برای نمونههای غذایی و محیطی هم مناسب است؟
بله، برای تشخیص سالمونلا از مواد غذایی، آب و نمونههای محیطی قابل استفاده است.

هنوز نظری ثبت نشده
اولین نفری باشید که نظر میدهید
ثبت نظر